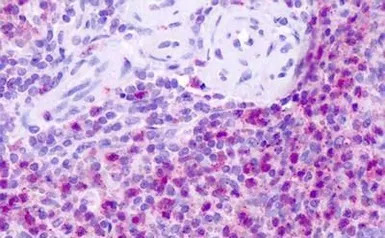
Neurokinin 1 Receptor antibody

相关产品推荐更多 >
万千商家帮你免费找货
0 人在求购买到急需产品
- 详细信息
- 文献和实验
- 技术资料
- 免疫原:
Synthetic 18 amino acid peptide from C-terminus of human Neurokinin 1 Receptor.
- 亚型:
IgG
- 形态:
Liquid
- 保存条件:
Store as concentrated solution. Centrifuge briefly prior to opening vial. For short-term storage (1-2 weeks), store at 4ºC. For long-term storage, aliquot and store at -20ºC or below. Avoid multiple freeze-thaw cycles.
- 克隆性:
Polyclonal
- 标记物:
Unconjugated
- 适应物种:
Human, Rat, Rabbit, Hamster, Guinea pig, Monkey, Horse
- 保质期:
12 months from the shipping date of the product.
- 抗原来源:
Human
- 目录编号:
GTX71743
- 级别:
Primary Antibodies
- 库存:
Available
- 供应商:
GeneTex
- 宿主:
Rabbit
- 应用范围:
IHC-P
- 浓度:
1 mg/ml (Please refer to the vial label for the specific concentration.)
- 靶点:
Neurokinin 1 Receptor
- 抗体英文名:
Neurokinin 1 Receptor antibody
- 抗体名:
Neurokinin 1 Receptor 抗体
- 规格:
25 μg
IHC-P analysis of human spleen tissue using GTX71743 Neurokinin 1 Receptor antibody.
Antigen retrieval : Heat-induced antigen retrieval
Dilution : 1-40 μg/ml

IHC-P analysis of human heart tissue using GTX71743 Neurokinin 1 Receptor antibody.
Antigen retrieval : Heat-induced antigen retrieval
Dilution : 1-40 μg/ml
风险提示:丁香通仅作为第三方平台,为商家信息发布提供平台空间。用户咨询产品时请注意保护个人信息及财产安全,合理判断,谨慎选购商品,商家和用户对交易行为负责。对于医疗器械类产品,请先查证核实企业经营资质和医疗器械产品注册证情况。
 文献和实验
文献和实验Aspects of CNS Lupus: Mouse Models of Anti-NMDA Receptor Antibody Mediated Reactivity
This chapter describes methods utilized in establishing a mouse model of neuropsychiatric lupus encompassing both cognitive and emotional dysfunction, and a model of the influence of maternal antibody on the developing brain. The antibody
人神经激肽A(Neurokinin A)ELISA试剂盒 说明书
上海西唐生物科技有限公司 021-55229872, 65333639 www.westang.com 人神经激肽A ( Neurokinin A )ELISA 试剂盒 ( 用于血清、血浆、细胞培养上清液和其它生物体液内 ) 原理 本实验采用双抗体夹心 ABC-ELISA 法。用抗人 Neurokinin A 单抗包被于酶标板上,标准
This work describes protocols for the production of single-chain antibody and T-cell receptor fragments inE. coli . A choice of methods is given for the purification of the recombinant fragments that rely on the use of either immunoaffinity
 技术资料
技术资料暂无技术资料 索取技术资料











